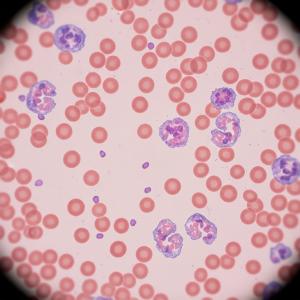
Thrombocytopenia Management Market Size

Thrombocytopenia Management Market Set to Reach US$ 6.53 Billion by 2033, Led by North America's 40% Market Share
Thrombocytopenia Management Market advances with novel therapies like TPO-RAs, rituximab, and corticosteroids tackling low platelet counts from ITP, chemo, and more.”
AUSTIN, TX, UNITED STATES, December 1, 2025 /EINPresswire.com/ -- According to DataM Intelligence, the Global Thrombocytopenia Management Market size is growing from US$ 4.15 billion in 2024 to US$ 6.53 billion by 2033, registering a steady CAGR of 5.2% during 2025–2033.— DataM Intelligence
The increasing prevalence of thrombocytopenia due to factors such as cancer therapies, chronic diseases, and autoimmune disorders is driving the demand for effective management solutions. Advances in platelet transfusion techniques, novel thrombopoietin receptor agonists, and improved diagnostic tools are enhancing patient outcomes and fueling market growth.
Furthermore, the rising awareness among healthcare professionals combined with expanded healthcare infrastructure in emerging markets is supporting wider adoption of thrombocytopenia treatments. Ongoing research aimed at developing safer and more targeted therapies underpins the market’s sustained expansion across hematology and oncology sectors.
Download your exclusive sample report today: (corporate email gets priority access): https://www.datamintelligence.com/download-sample/thrombocytopenia-management-market
Latest Key Industry Developments
-Sanofi's Wayrilz (rilzabrutinib), the first BTK inhibitor for treating immune thrombocytopenia, received FDA approval for adults with persistent or chronic immune thrombocytopenia, marking a significant new treatment option in the market.
- The FDA approved Wayrilz, highlighting a trend toward more personalized, oral treatments for immune thrombocytopenia management, alongside existing thrombopoietin receptor agonists and immune modulators.
-PL BioScience and DewCell Biotherapeutics sign an LOI: In October 2025, PL BioScience, a life science company focused on Human Platelet Lysate, signed a Letter of Intent (LOI) with Korean firm DewCell Biotherapeutics to supply artificial platelet-derived raw materials, strengthening collaboration in regenerative medicine that could impact platelet disorder treatments.
- PwC notes continued M&A in Health Tech: A mid-year outlook report in June 2025 (reporting Q3 expectations) highlighted expectations for increased M&A activity in health tech, particularly AI-driven diagnostics, which will affect the management of conditions like thrombocytopenia through improved diagnostic accuracy and speed.
-Sobi receives FDA approval for Doptelet in pediatric patients: Sobi announced in July 2025 that the FDA approved Doptelet (avatrombopag) for children aged one year and older with chronic ITP who have had insufficient responses to previous treatments.
Market Growth Drivers:
-The rising prevalence of thrombocytopenia linked to cancer therapies like chemotherapy and radiation, along with increasing incidences of autoimmune disorders such as immune thrombocytopenia (ITP) and chronic conditions including hepatitis C and liver diseases, represents a primary force driving market expansion. Novel thrombopoietin receptor agonists (TPO-RAs) like eltrombopag and romiplostim offer effective platelet-boosting alternatives to traditional steroids, enabling better long-term management and reducing reliance on transfusions. Advancements in targeted therapies, including FcRn inhibitors, Syk inhibitors like fostamatinib, and biologics, are accelerating R&D efforts to address treatment-resistant cases and improve platelet recovery rates.
-The surge in oncology patient populations undergoing bone marrow-suppressive treatments and growing awareness of early diagnosis through improved hematology diagnostics are broadening the application scope of thrombocytopenia management solutions. Government support via financial aids, reimbursement policies, and orphan drug pathways in developed markets further enhances accessibility, particularly for secondary thrombocytopenia in emerging regions. Regulatory expansions for biomarker-guided approvals and biosimilars are also optimizing cost-effectiveness and market penetration.
-The global shift toward personalized, multimodal treatment paradigms—integrating immunomodulation, oral self-administered options, and telehematology platforms—strengthens overall market growth as healthcare systems prioritize rapid platelet improvement, reduced hemorrhagic risks, and value-based care models across hospitals and community settings.
Segmentation Analysis
-By Treatment Type
The market is segmented into Pharmacological Treatment, Supportive Care, and Plasmapheresis. Pharmacological treatments include thrombopoietin receptor agonists (TPO-RAs) such as eltrombopag and romiplostim, corticosteroids, intravenous immunoglobulins, and novel biologics targeting immune modulation. Supportive care covers platelet transfusions and symptomatic management, often used in acute and severe cases. Plasmapheresis is primarily employed in thrombotic thrombocytopenic purpura (TTP) patients to remove autoantibodies, representing a specialized, invasive treatment segment.
-By Disease Type
The disease type segmentation comprises Idiopathic Thrombocytopenic Purpura (ITP), Thrombotic Thrombocytopenic Purpura (TTP), Drug‑induced Thrombocytopenia, and Others, including secondary thrombocytopenia caused by infections or chronic diseases. ITP is the dominant segment driven by its chronic nature and rising prevalence. TTP requires emergency interventions and specialized therapies such as plasmapheresis. Drug-induced thrombocytopenia arises from chemotherapy and other medications, necessitating different management approaches compared to primary immune disorders.
-By Distribution Channel
Distribution channels include Hospital Pharmacies and Retail Pharmacies. Hospital pharmacies dominate the market due to the acute administration and monitoring needs of thrombocytopenia treatments, especially for intravenous drugs and plasmapheresis-related supplies. Retail pharmacies are gaining importance with the increased availability of oral pharmacological therapies and home-based management options, improving patient compliance and accessibility.
Buy Now & Unlock 360° Market Intelligence: https://www.datamintelligence.com/buy-now-page?report=thrombocytopenia-management-market
Regional Insights:
-The North America region holds the largest market share in the Thrombocytopenia Management Market, commanding more than 50% of the market. This dominance is driven by a well-established healthcare infrastructure, higher prevalence of thrombocytopenia, availability of FDA-approved treatments like thrombopoietin receptor agonists, and strong emphasis on clinical research and novel therapies. The United States leads clinical studies and expanded use of therapies for thrombocytopenia, supporting sustained growth in this region.
-Europe follows North America in market share, holding a substantial portion due to similar factors such as advanced healthcare infrastructure, significant healthcare expenditure, and regulatory frameworks that facilitate the adoption of new treatments. Europe’s market dynamics mirror those of North America, contributing to its strong position in the global market.
-Asia-Pacific is expected to show considerable growth and emerging presence in the market, driven by a large and growing population, increasing healthcare investment, rising awareness of thrombocytopenia, and improving access to healthcare services. Although Asia-Pacific’s current market share is lower than North America and Europe, its growth potential is significant owing to expanding patient populations and rising healthcare expenditure.
Competitive Landscape
-The Thrombocytopenia Management Market is competitive with key players like Novartis, Amgen, Sanofi, Takeda, Pfizer, Teva Pharmaceuticals, and Rigel leading the space. These companies drive innovation through new drug approvals such as thrombopoietin receptor agonists (TPO-RAs), biologics for immune thrombocytopenia (ITP), and expanded therapies for chemotherapy-induced cases, alongside global market expansion via strategic partnerships and manufacturing scale-up.
-Amgen and Novartis focus on next-generation TPO mimetics and targeted immunomodulators, while Sanofi and Takeda emphasize pipeline advancements in orphan indications and biosimilars to address unmet needs in cancer-associated thrombocytopenia. Pfizer and Teva Pharmaceuticals bolster their portfolios with generics and supportive care solutions, and Rigel advances novel kinase inhibitors like fostamatinib for refractory ITP. Investment in gene therapies, personalized dosing, and real-world evidence studies is intensifying across the sector.
-Collaborations with academic institutions, regulatory accelerations for orphan drugs, and ongoing R&D in FcRn inhibitors and Syk inhibitors enhance treatment efficacy and patient access, positioning these firms as leaders in a market evolving toward multimodal and precision-based thrombocytopenia management.
Get Customization in the report as per your requirements: https://www.datamintelligence.com/customize/thrombocytopenia-management-market
Conclusion:
The Thrombocytopenia Management Market is poised for sustained growth through innovative therapies like TPO-RAs and targeted biologics, addressing rising ITP and chemotherapy-induced cases. Enhanced diagnostics and personalized approaches will improve patient outcomes globally, particularly in emerging markets.
Related Reports:
1. Thrombectomy Devices Market - expected to reach US$ 2.31 billion by 2031.
2.Industrial Safety Market - expected to grow at a CAGR of 7.20% during the forecast period (2024-2031).
Sai Kiran
DataM Intelligence 4market Research LLP
+1 877-441-4866
email us here
Visit us on social media:
LinkedIn
X
Legal Disclaimer:
EIN Presswire provides this news content "as is" without warranty of any kind. We do not accept any responsibility or liability for the accuracy, content, images, videos, licenses, completeness, legality, or reliability of the information contained in this article. If you have any complaints or copyright issues related to this article, kindly contact the author above.